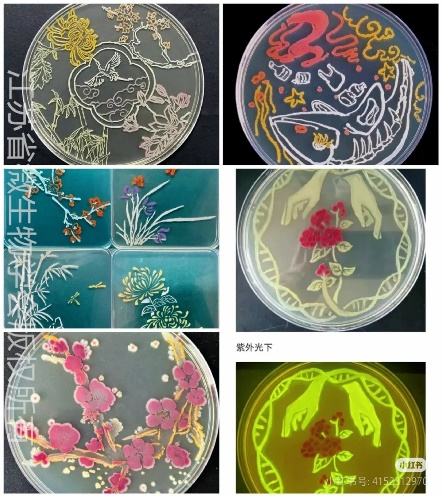

大连理工大学,作为首批入选强基计划的试点高校之一,始终坚守着教育使命——致力于为国家培育基础学科领域的拔尖人才以及能够引领国家战略创新的栋梁之材。在这里,学校精心遴选出自身极具优势的基础学科,巧妙地将其与实力强劲的工科专业相互融合,打破学科界限,碰撞出创新的火花。同时,学校秉持着高瞻远瞩的教育理念,统筹规划设计出一套贯穿本科、硕士直至博士阶段的衔接式培养体系,为每一位学子量身打造成长路径,全方位助力学生在学术造诣、科研能力、实践技能以及综合素质等诸多方面实现飞跃式发展,向着未来的无限可能大步迈进。
“连理大工,筑梦未来”
大连重点中学强基计划探索之旅
(生物工程专场)
时间:2025年2月5日(正月初八)
地点:大连理工大学凌水主校区
(辽宁省大连市凌工路2号)

此次活动面向大连重点中学及其满怀期待的家长们,以“连理大工 筑梦未来—大连重点中学强基计划探索之旅”为名,精心筹备,诚意满满。
从学科介绍、政策讲解、专业探索等方面,多角度、全方位的带你感受大工强基计划的独特风采,真正触摸到梦想的温度,开启属于自己的筑梦之旅。
日程安排
时间
2025年2月5日(正月初八)
14:00-16:30
开幕式
主持
生物工程学院副书记、副院长赵婷婷老师
大连理工大学招生政策解读
01
报告人
大连理工大学招办主任 李琳
科普讲座及专业介绍
02
讲座人
生物工程学院党委书记杨君教授
讲座人介绍

杨君教授,博士生导师。辽宁省生物实验教学示范中心主任、辽宁省动物学会副理事长、辽宁省细胞生物学会先进医工融合技术专业委员会常务理事,辽宁省生命科学学会理事,大连理工大学大数据与人工智能伦理法律与社会研究中心研究员。近年来,主持国家自然科学基金面上项目、国家重点研发子课题项目、省市基金/计划项目多项,参与国家973、863、自然科学基金重点项目等多项。

杰出校友,科普达人
03
尹烨线上解读
“AI+BT时代已来,我们该做什么?”
报告人介绍
尹烨,华大集团CEO。哥本哈根大学博士,基因组学研究员,大连理工大学兼职教授,第三届中国人类遗传资源管理专家组成员,中国计量测试学会生物计量专业委员会委员,中国抗癌协会肿瘤科普防治专业委员会常务委员,国际标准化组织生物技术委员会专家,国际标准化组织医学实验室检验和体外诊断系统技术委员会专家,“一带一路”生命科技促进联盟常务副理事长,粤港澳大湾区标准创新联盟主席,广东省传染病诊断试剂产业技术创新联盟理事长,深圳市标准化协会第七届理事会会长。
他是“非典”科研攻关主要参与者之一,曾当选最年轻的中国杰出质量人、华大基因全球化布局推动者、华大基因收购CG项目核心成员、率领华大基因成功登陆创业板。
2020年全球遭遇新冠病毒疫情,他被任命为华大基因的新冠疫情防控总指挥官,带领华大上下数千人战斗在国内及海外抗疫最前线,并将公司研发的检测试剂盒推广到全球180多个国家和地区,累计在海外启动运营“火眼”实验室超过90个。他心系公益事业,组建面向罕见病群体的机构“同病相联”,和团队一起成立救助遗传病的“华基金”“光基金”,带领团队发起多项罕见病救助计划。他是媒体圈、财经圈、科研圈最受欢迎的生物界“名嘴”,也是传播生命科学的科普工作者。为讲述大众“听得懂的生命科学”。


智能生物制造
教育部重点实验室参观
04
带你近距离走进智能生物制造教育部重点实验室,从高通量筛选的自动化精密分析仪器到原子力显微镜和3D生物材料打印设备,为同学们科研之路提供高水平仪器设备平台。顶尖的师资团队,带领同学们攀登合成生物学、基因编辑、生物医药等领域科研高峰。


看到不一样的微观世界——微
实验体验:荧光蛋白菌体绘画
05

通过含有荧光蛋白的细菌(无毒无害)进行作画,使其在生长过程中培养并完成绘画创作,将培养皿变成画布,实现荧光微生物与艺术的完美结合。
未来技术学院
智能生物工程共享空间参观
06


项目证明
为学员颁发2025年“连理大工 筑梦未来”大连理工大学强基计划探索之旅研学证书、书夹。
✦
•
✦





✦
左右滑动,查看更多
✦
报名方式
扫描下方二维码进行预约

名额有限,先到先得!


高招云直播